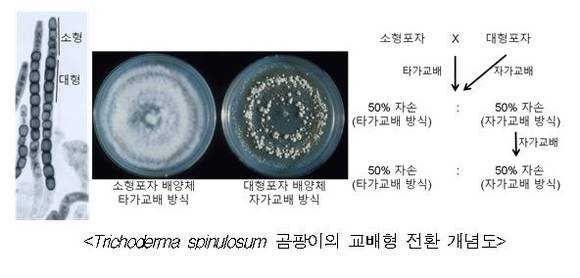

최근 곰팡이의 교배형전환(mating type switching)에 의한 자가교배 메커니즘을 규명해 관심을 끈다. 산업적으로 유용한 곰팡이의 균주 개량과 붉은곰팡이에 의한 식물병 발생 생태 예측과 신개념의 방제 전략을 수립할 수 있을 것으로 기대된다.
농림식품기술기획평가원(원장 오경태)는 ‘미생물유전체 연구를 통해 사상성 곰팡이의 유성성식에서 곰팡이의 생존과 전파에 필수적인 교배형 전환 (mating type switching) 메커니즘을 세계 최초로 규명했다’고 발표했다.
농식품부는 농식품 유용미생물의 유전자원을 발굴해 실용화, 산업화를 촉진하기 위해 포스트게놈 다부처 유전체사업의 일환으로 농림축산식품 미생물유전체전략연구사업단(사업단장 : 김지현 연세대학교 교수)을 선정해 농식품 미생물유전체 연구를 지원하고 있다.
사업단의 순천향대학교 의료생명공학과 윤성환 교수 연구진은 미국 Cornell 대 연구진과 공동연구를 통해 사상성 곰팡이의 독특한 자손 생산 방식인 교배형 전환(mating type swichting)에 의한 자가교배의 메커니즘을 세계 최초로 규명했다.
이번 연구결과에 따르면 모델 사상성 곰팡이인 Trichoderma spinulosum 은 서식 환경 내 생존과 자손 전파를 위해 자가교배 방식으로 자손(포자)을 생산한다. 이때 50%의 자손은 자가 교배능을 상실해 타가교배능만 유지하는 반면, 나머지 50%의 자손은 자가 교배에 의해 후속 세대 자손을 생산할 수 있다. 하지만 이 경우도 50%의 후속 세대는 자가교배능을 상실한다.
이와 같은 교배형 전환의 메커니즘을 규명하기 위해 Trichoderma spinulosum 을 비롯한 근연종의 교배형 염색체 구조와 기능을 유전체학 수준에서 분석한 결과, Trichoderma spinulosum는 영양생장 동안 성염색체 내 상동성 재조합 (homologous recombination) 과정에 의해 원래 보유한 두 가지 교배형 유전자 (MAT1-1 과 MAT1-2) 중 한 가지 (MAT1-2)를 상실함이 밝혀졌다. 결국 이 곰팡이의 자가교배는 세포 수준에서 서로 다른 교배형 핵 (nuclei) 사이의 융합 (karyogamy)에 의해 이뤄짐이 밝혀졌다.
사상성 곰팡이의 유성생식은 우수한 자손의 생산뿐 아니라, 병원성 곰팡이의 경우 불리한 서식 환경 내 생존력 증대와 동식물 기주 감염에 필수적이다.
이번 연구에서 사용한 Trichoderma 속 곰팡이는 다양한 항균물질과 효소 생산능이 뛰어날 뿐 아니라 주요 식물병원균인 붉은곰팡이 (Fusarium graminearum)와 유사한 교배형 염색체 구조를 가지고 있다.
연구 결과는 기초 분야에서 곰팡이 뿐 아니라 고등 생물의 유성생식 과정과 성염색체 진화의 이해에 중요한 기여를 할 것으로 기대되며 응용 분야에서 산업적으로 유용한 곰팡이의 균주 개량과 붉은곰팡이에 의한 식물병 발생 생태 예측 및 새로운 개념의 방제 전략 수립에 중요 기반으로 활용될 수 있을 것이다.
이번 연구는 유전학 분야의 세계적 학술지인 플로스 제네틱스(PLOS Genetics) 온라인판에 9월 21일자에 게재됐다.
이원식 기자의 전체기사 보기
Copyright @보건신문 All rights reserved.





















